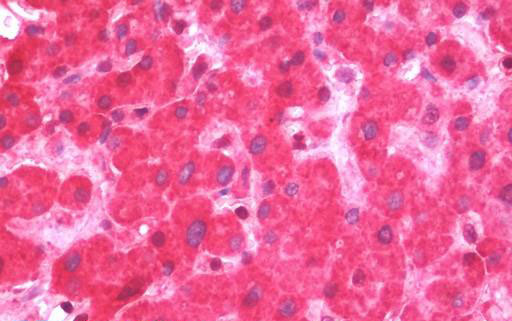

> Antigen, Antibodies, ELISA, Western Blot > Primary Antibody > Polyclonal Antibodies > FSP27 / CIDEC AntibodyBrand |
Leading Biology | Catalog Number |
APR03302G |
Product Type |
Polyclonal Antibodies | Field of Research |
|
Product Overview |
We constantly strive to ensure we provide our customers with the best antibodies. As a result of this work we offer this antibody in purified format.
We are in the process of updating our datasheets. If you have any questions regarding this update, please feel free to contact our technical support team.
This product is a high quality FSP27 / CIDEC Antibody.
|
||
Molecular Weight |
26754 Da
|
||
Cellular Localization |
Antigen Cellular Localization:
Nucleus. Endoplasmic reticulum. Lipid droplet. Note=Diffuses quickly on lipid droplet surface, but becomes trapped and clustered at lipid droplet contact sites, thereby enabling its rapid enrichment at lipid droplet contact sites
|
||
Host |
Rabbit
|
||
Species Reactivity |
Human
|
||
Target |
Human CIDEC / FSP27
|
||
Isotype |
IgG
|
||
Symbol |
FSP27
|
||
GeneID |
|||
UniProt ID |
|||
Function |
Binds to lipid droplets and regulates their enlargement, thereby restricting lipolysis and favoring storage. At focal contact sites between lipid droplets, promotes directional net neutral lipid transfer from the smaller to larger lipid droplets. The transfer direction may be driven by the internal pressure difference between the contacting lipid droplet pair. Its role in neutral lipid transfer and lipid droplet enlargement is activated by the interaction with PLIN1. May act as a CEBPB coactivator in the white adipose tissue to control the expression of a subset of CEBPB downstream target genes, including SOCS1, SOCS3, TGFB1, TGFBR1, ID2 and XDH. When overexpressed in preadipocytes, induces apoptosis or increases cell susceptibility to apoptosis induced by serum deprivation or TGFB treatment. As mature adipocytes, that express high CIDEC levels, are quite resistant to apoptotic stimuli, the physiological significance of its role in apoptosis is unclear. May play a role in the modulation of the response to osmotic stress by preventing NFAT5 to translocate into the nucleus and activate its target genes expression.
|
||
Summary |
Binds to lipid droplets and regulates their enlargement, thereby restricting lipolysis and favoring storage. At focal contact sites between lipid droplets, promotes directional net neutral lipid transfer from the smaller to larger lipid droplets. The transfer direction may be driven by the internal pressure difference between the contacting lipid droplet pair. Its role in neutral lipid transfer and lipid droplet enlargement is activated by the interaction with PLIN1. May act as a CEBPB coactivator in the white adipose tissue to control the expression of a subset of CEBPB downstream target genes, including SOCS1, SOCS3, TGFB1, TGFBR1, ID2 and XDH. When overexpressed in preadipocytes, induces apoptosis or increases cell susceptibility to apoptosis induced by serum deprivation or TGFB treatment. As mature adipocytes, that express high CIDEC levels, are quite resistant to apoptotic stimuli, the physiological significance of its role in apoptosis is unclear. May play a role in the modulation of the response to osmotic stress by preventing NFAT5 to translocate into the nucleus and activate its target genes expression.
|
||
Storage & Stability |
Store at +4°C short term. For long-term storage, aliquot and store at -20°C or below. Stable for 12 months at -20°C. Avoid repeated freeze-thaw cycles.
|
||
Applications |
WB, IHC-P, IF, ICC
|
||
Dilution |
ICC (1:100 - 1:1000), IF (1:100 - 1:1000), IHC-P (7.5 μg/ml), WB (1:500 - 1:3000),
|
||
Images |
Anti-FSP27 / CIDEC antibody IHC staining of human liver. 
CIDEC antibody detects CIDEC protein at cytoplasm by immunofluorescent analysis. 
Sample (30 ug of whole cell lysate) A: HeLa B: HepG2 12% SDS PAGE CIDEC / FSP27 antibody diluted... |
||
Specification |
|||
Quantity |
|
||
| Select | Brand | Catalog No. | Product Name | Pack Size | Type | Field of Research | Specification | Quantity | Price(USD) | |
| 1 | Leading Biology | APR03440G | ITGA11 Antibody (N-term) | 100 μl | Polyclonal Antibodies |
|
$495.00 | Add Ask | ||
| 2 | Leading Biology | APR04537G | CMIP Antibody (C-term) | 100 μl | Polyclonal Antibodies |
|
$495.00 | Add Ask | ||
| 3 | Leading Biology | APR12422G | Human H4 Histamine Receptor (extracellular) Antibody | 50 μl | Polyclonal Antibodies |
|
$695.00 | Add Ask | ||
| 4 | Leading Biology | APR03844G | UBE2W Antibody (C-term) | 100 μl | Polyclonal Antibodies |
|
$495.00 | Add Ask | ||
| 5 | Leading Biology | APR04349G | HECTD2 Antibody (N-term) | 100 μl | Polyclonal Antibodies |
|
$495.00 | Add Ask | ||
| 6 | Leading Biology | APR03502G | IGHG1 Antibody (Center) | 100 μl | Polyclonal Antibodies |
|
$495.00 | Add Ask |
 Leading Biology Inc.
2600 Hilltop DR, Building G, B Suite C138
Richmond, CA, 94806
Tel: 1-661-524(LBI)-0262
Email: info@leadingbiology.com
Leading Biology Inc.
2600 Hilltop DR, Building G, B Suite C138
Richmond, CA, 94806
Tel: 1-661-524(LBI)-0262
Email: info@leadingbiology.com
Complete this form and click send to ask us a question, request a quote or simply say hello.

You have 0 item in your cart

You have 0 item in your inquiry list
